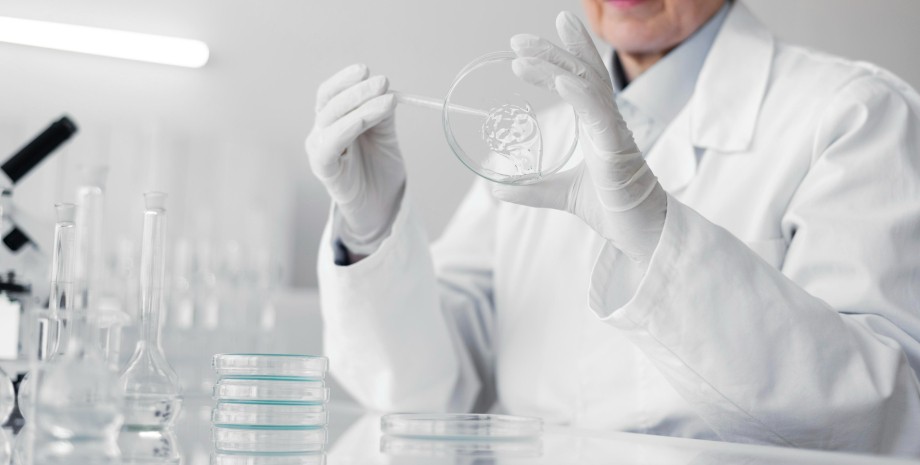

Діджитал Дорогі метали не потрібні: знайдено новий метод видобутку зеленого водню
Заміна металів платинової групи в електролізері на більш доступні матеріали дає змогу зробити виробництво водню дешевшим.
Related video
Команда дослідників ANEMEL створила ефективний і стабільний каталізатор для розщеплення води, який дає змогу зробити виробництво зеленого водню шляхом електролізу дешевшим. Про це пише портал Tech Xplore.
Як пояснюють у виданні, сучасні електролізери з аніонообмінною мембраною використовують рідкісні та дорогі метали платинової групи (PGM). Вони потрібні як каталізатори на катоді, де генерується водень.
Зі свого боку вчені з ANEMEL використовують замість металів платинової групи більш поширені метали, такі як нікель. Це допомагає знизити вартість компонентів електролізера і поліпшити їхню перероблюваність, роблячи виробництво водню дешевшим.
Дослідники виростили каталізатор із нікелю та молібдену. Цю комбінацію металів уже використовували з такою метою раніше, проте новизна полягає в методі та змінних, задіяних у досягненні високоефективного каталізатора.
У своєму новому дослідженні вчені описують, як створили каталізатор із нікелю та молібдену — двох поширених металів. Цю комбінацію металів уже використовували раніше в подібних реакціях, однак новизна полягає в методі та змінних, необхідних для отримання високоефективного каталізатора.
Важливо Змінить авіацію: створено перший турбінний двигун, що працює на рідкому водні
"Я працюю над цим каталізатором уже довгий час. Ця робота накопичувалася з плином часу — ми оптимізували метод, склад ванни електроосадження та підкладки, які ми використовуємо для газодифузійного шару", — розповіла наукова співробітниця-докторантка ANEMEL Аріана Сербан.
Повідомляється, що отриманий каталізатор дозволив електролізерам стабільно працювати за щільності струму до 3 А/см². Ця продуктивність порівнянна з еталонними платиновими каталізаторами, навіть з трохи вищою стабільністю. За словами Аріани Сербан, цей результат входить до топ-100 або навіть топ-50 з точки зору продуктивності для каталізаторів без PGM.
Нагадаємо, група вчених із Пхоханського університету науки і технології (POSTECH) у Південній Кореї розробила новаторську технологію, яка усуває ключові обмеження у виробництві чистого водню, використовуючи мікрохвилі.
Зі свого боку дослідники з Массачусетського технологічного інституту розробили інноваційний спосіб отримання водневого палива з використанням алюмінію і морської води.
